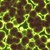
Масовото ваксиниране може да ни спаси от антимикробна резистентност

Пътуващите в чужбина са по-уязвими за резистентни на антибиотици бактерии
- Редактор: Мирослава Бонева
- Коментари: 0

Хората, пътуващи в чужбина, са особено уязвими на по-опасните щамове бактерии, резистентни на различни лекарства
Когато прекарват време в компанията на други туристи, те често се заразяват с различни типове по време на своите пътешествия, сочи ново изследване, пише Обекти.
Глобалното разпространение на чревните грам-отрицателни мултирезистентни микроби (MDR-GN) представлява сериозна заплаха за човешкото здраве в световен мащаб.
MDR клонингите на Ешехерия коли и Клебсиела пневмония например са отговорни за все по-голям брой инфекции, които не подлежат на лекуване с антибиотици.
За да достигнат до тези заключения, учените са наблюдавали европейски туристи, които са посетили Лаоската народнодемократична република за три седмици. Те са анализирали ежедневно проби от техните изпражнения, за да получат по-прецизна картина за здравето на стомашно-чревния им тракт.
Оказва се, че бактериални щамове са създали свои колонии в множество туристи, отседнали в едни и същи хотели (и прекарващи времето си заедно).
В един изолиран случай двама от участниците в проучването, настанени на отделни места, са споделяли идентичен щам, след като единият от тях се е изкъпал в банята на другия.
Международният екип от изследователи, ръководен от учени от университетите на Базел, Бирмингам, Хелзинки и Осло, както и института „Сангер“, са публикували своите открития в научното издание The Lancet Microbe.
„Пътуването на чужбина е тясно свързано с разпространението на MDR-GN бактерии, като рискът от предаването им е най-високо в Индия, югоизточна Азия, Африка и Южна Америка“, казва професорът по микробна еволюционна геномика Алън Макнали от Бирмингамския университет, който е и старши автор на проучването.
Пътешествениците, посещаващи тези високорискови региони, са изложени на значителен риск и могат да прихванат въпросните бактерии.
„Бактериалната MDR-GN колонизация е изключително динамичен процес – казва още той. – Открихме, че съществува постоянното „съревнование“ между циркулиращите щамове, придобити от конкретния пътешественик, и неговите „родни“ бактерии.“
Въздействието на пътуването върху глобалното разпространение на мултирезистентната Ешехерия коли е добре документирано – до 80 процента от пътешествениците, връщащи се от високорискови региони, са колонизирани от MDR-GN бактерии (като самата колонизация трае до една година). Предишни проучвания, проведени върху хората, пътуващи в чужбина, анализират единствено проби, взети преди и след самото пътешествие, но не и по време на самия престой в дадената държава.
Изследователите откриват, че в края на проучването 70 процента от двадесетимата доброволци, посетили Лаос, са били колонизирани от въпросните бактерии. Ежедневните проби, предоставяни от тях, показват, че в определен момент от своя престой всички участници са се сдобили с разширен спектър на бета-лактамази (ESBL).
ESBL ензимите създават резистентност в рамките на тялото към повечето β-лактамни антибиотици като например пеницилини, цефалоспорини, цефамицини и карбапенеми.
Всички участници (без един) са се сдобили с множество щамове на бактерия. Разпознати са 83 уникални щама (53 на Ешехерия коли, 10 на Клебсиела пневмония и 20 други ESBL-GN видове). Някои от тези щамове са били споделяни между до четирима души.

Община Русе търси главен експерт по екология
Пенчо Милков: Асфалтираме улица след 30 години разруха
Пенчо Милков: Асфалтираме улица след 30 години разруха
Пенчо Милков: Асфалтираме улица след 30 години разруха
Скандал заради закриване на паралелка в МГ "Баба Тонка"